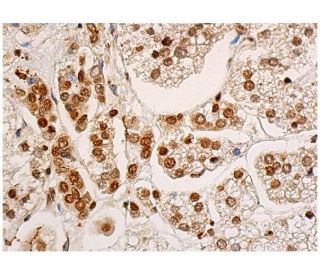
immunohistochemistry image from recommended SF-1 (A-1) monoclonal antibody replacement. Image 343941

Informazioni ordini
SF-1 (A-1): sc-393592 [ Monoclonale raccomandato come sostituzione per SF-1 (E-18) ]
| Nome del prodotto | Codice del prodotto | UNITÀ | Prezzo | Quantità | Preferiti | |
SF-1 Anticorpo (A-1) | sc-393592 | 200 µg/ml | $322.00 | |||
SF-1 (A-1): m-IgG Fc BP-HRP Bundle | sc-530515 | 200 µg Ab; 10 µg BP | $361.00 | |||
SF-1 (A-1): m-IgGκ BP-HRP Bundle | sc-524018 | 200 µg Ab, 40 µg BP | $361.00 | |||
SF-1 (A-1): m-IgG2a BP-HRP Bundle | sc-547514 | 200 µg Ab; 10 µg BP | $361.00 | |||
SF-1 Anticorpo (A-1) X | sc-393592 X | 200 µg/0.1 ml | $322.00 | |||
SF-1 Anticorpo (A-1) AC | sc-393592 AC | 500 µg/ml, 25% agarose | $424.00 | |||
SF-1 Anticorpo (A-1) HRP | sc-393592 HRP | 200 µg/ml | $322.00 | |||
SF-1 Anticorpo (A-1) FITC | sc-393592 FITC | 200 µg/ml | $336.00 | |||
SF-1 Anticorpo (A-1) PE | sc-393592 PE | 200 µg/ml | $349.00 | |||
SF-1 Anticorpo (A-1) Alexa Fluor® 488 | sc-393592 AF488 | 200 µg/ml | $364.00 | |||
SF-1 Anticorpo (A-1) Alexa Fluor® 546 | sc-393592 AF546 | 200 µg/ml | $364.00 | |||
SF-1 Anticorpo (A-1) Alexa Fluor® 594 | sc-393592 AF594 | 200 µg/ml | $364.00 | |||
SF-1 Anticorpo (A-1) Alexa Fluor® 647 | sc-393592 AF647 | 200 µg/ml | $364.00 | |||
SF-1 Anticorpo (A-1) Alexa Fluor® 680 | sc-393592 AF680 | 200 µg/ml | $364.00 | |||
SF-1 Anticorpo (A-1) Alexa Fluor® 790 | sc-393592 AF790 | 200 µg/ml | $364.00 | |||
SF-1 (A-1) peptide neutralizzante | sc-393592 P | 100 µg/0.5 ml | $69.00 |